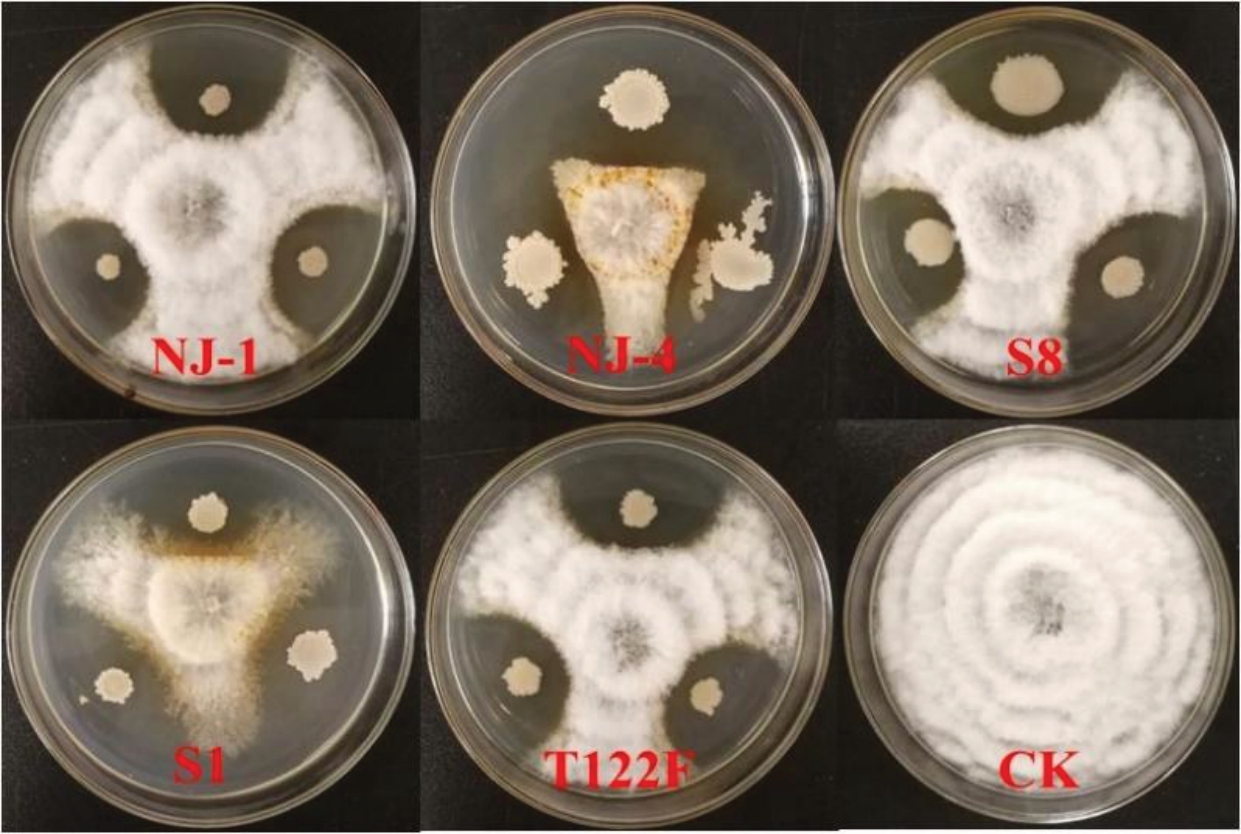

枇杷(Eriobotrya japonica Lindl.)起源于中国,是我国南方部分地区的重要特色果树,规模种植经济效益高。随着我国枇杷栽培面积和范围的不断扩大,枇杷病害发生日益严重,尤其是叶斑病的发生常导致树势早衰、果实产量和品质下降。2023—2024年西藏墨脱枇杷种植区的调查显示,枇杷叶斑病普遍发生,局部地区危害较重,严重时叶片畸形、呈焦枯状、早衰易脱落,对当地枇杷产业发展造成一定的影响。据报道,引起枇杷叶斑病的病害种类较多,包括圆斑病、灰斑病、轮纹病、炭疽病、叶尖焦枯病、斑点病等[1-2],明确西藏墨脱地区枇杷叶斑病病害种类及致病菌,对该病害的合理有效防控具有重要的指导意义。1999 年,Perelló 等[3]在阿根廷鉴定枇杷叶斑病致病菌为Pestalotiopsis guepinii;Chen 等[4]2013年和Xiao 等[5]2016 年分别在安徽省泾县、黄山市鉴定枇杷叶斑病致病菌为P. theae 和P. microspora;2014 年,张斌等[2]认为引起贵阳地区枇杷叶斑病的致病菌有P. funereaa、Phyllosticta eriobatryae、Glomerella cingulata 和Ascochyta eriobotryae;而张丹华等[6]对重庆地区枇杷叶斑病病样进行病原菌分离,鉴定病原菌为Alternaria alternate,这表明不同地区的枇杷叶斑病病原菌存在差异。
化学防治是当前防治枇杷叶斑病的主要措施,具有见效快、成本低等优点。已有研究表明,在田间枇杷新梢萌发期和展叶期喷施50%多菌灵·施保功可湿性粉剂1.00 kg·hm-2、68%多菌灵·代森锰锌可湿性粉剂2.50 kg·hm-2 对枇杷叶斑病防效分别为93.27%和80.34%[7],喷施25%咪鲜胺乳油833 倍液对枇杷叶斑病防效可达83.80%[8]。室内毒力测定发现枇杷叶斑病菌对戊唑醇、丙森锌和腈菌唑敏感[9]。然而,长期大量施用化学农药易导致农药残留及环境污染,拮抗细菌因对病原菌特异性强且具环境安全性,受到了广泛关注,以菌治病的生物防治技术在植物病害防治中发挥重要作用[10-12]。目前,国内利用芽孢杆菌防治植物病害的应用研究取得显著成效,已成功开发并投入生产的商品制剂有亚宝、百抗、麦丰宁、纹曲宁等[13]。生物防治是保障植物病害可持续防治、产业健康发展、农产品生产质量安全的重要手段,利用生防菌防治枇杷病害,将成为枇杷绿色产业发展中的新兴领域。然而,有关枇杷病害的生物防治研究相关报道较少。
西藏墨脱地区位于我国西南部,与印度比邻,四面环山,独特的生态气候环境条件非常适宜枇杷绿色产业发展。由于当地政府在枇杷生产过程中不提倡使用化学农药,急需一套有效的枇杷叶斑病非化学药剂防控措施。目前,西藏墨脱地区枇杷叶斑病的病原尚不明确,病害发生规律及其生物防治技术相关研究缺乏。笔者通过对西藏墨脱地区的枇杷叶斑病病样进行病原菌分离和鉴定,并采用平板对峙法测定拮抗细菌对病原菌的抑菌活性,研究其发酵液对病害的防控效果,旨在为该地区枇杷叶斑病安全有效的绿色防控提供参考。
1 材料和方法
1.1 材料
1.1.1 样品采集 分别于2023 年7 月、2023 年9 月及2024 年6 月从西藏墨脱县德兴村、玛迪村、西让村、地杀村、背崩村、荷扎村、米日村7 个枇杷种植区共采集100份枇杷叶斑病病样。
枇杷叶片采自福建省农业科学院果树研究所国家果树种质福州枇杷圃,选取健康、成熟的新叶;枇杷果实采自福清一都生态枇杷园,选取健康的套袋果。试验所用叶片和果实均未施用任何杀菌剂。
1.1.2 引物 TIS1/TIS4、NMS1/NMS2、T1/T22 和EF1/EF2 引物分别用于扩增真菌DNA 核糖体内转录间隔区(internal transcribed spaces,ITS)、线粒体中核糖体小亚基(mtSSU)、微管蛋白(β-tubulin,TUB)和翻译伸长因子(translation elongation factor 1α,TEF-1α)。引物信息见表1,引物委托生工生物工程(上海)股份有限公司合成。
表1 分子鉴定引物信息
Table 1 Information of primers for molecular identification

Note:R=A/G;S=G/C。
基因名称Gene name rDNA-ITS退火温度Tm/℃55片段长度Fragment length/bp 500参考文献Reference[14-16]mtSSU 50 550[17]TUB 52 750[18]TEF-1α引物名称Primers name ITS1 ITS4 NMS1 NMS2 T1 T22 EF1 EF2序列(5'-3')Sequences (5'-3')TCCGTAGGTGAACCTGCGG TCCTCCGCTTATTGATATGC CAGCAGTGAGGAATATTGGTCAATG GCAGATCATCGAATTAAATAACAT ATGCGTGAGATTGTAAGT GACCGAAAACGAAGTTGTC ATGGGTAAGGARGACAAGAC GGARGTACCAGTSATCATGTT 53 400[19-20]
1.1.3 拮抗细菌 NJ-1和S8(解淀粉芽孢杆菌Bacillus amyloliquefaciens)、NJ-4 和S1(贝莱斯芽孢杆菌Bacillus velezensis)、T122F(枯草芽孢杆菌Bacillus subtilis)由福建省农业科学院植物保护研究所提供。
1.1.4 杀菌剂 450 g·L-1咪鲜胺(prochloraz)水乳剂,山东邹平农药有限公司;10%的苯醚甲环唑(di-fenoconazole)可湿性粉剂,先正达南通作物保护有限公司。
1.1.5 培养基 PDA 培养基:马铃薯200 g、葡萄糖20 g、琼脂15 g、水1000 mL,pH 自然;LB 液体培养基:胰蛋白胨10 g、酵母提取物5 g、氯化钠10 g、水1000 mL、pH=7.0。
1.2 方法
1.2.1 病原菌分离纯化 采用常规组织分离法从具有典型症状的病叶上分离病原菌,在叶片病健交界处剪取大小约为5 mm 的组织块,用无菌水清洗3次,75%乙醇表面消毒45 s,再用无菌水洗涤3 次后转移到含利福平的PDA培养基,25 ℃黑暗培养12 d,对分离的病原菌进行单孢分离纯化[21],于4 ℃冰箱保存备用。
1.2.2 病原菌致病性检测 将分离纯化的病原菌转移至PDA 培养基,25 ℃黑暗培养12 d 后,用无菌水冲洗孢子,配制成浓度为1×105个·mL-1的孢子悬浮液,病原菌致病性检测参考文献[6]的方法。将采集的新鲜枇杷叶片经无菌水清洗晾干后,使用灭菌接种针在叶脉两侧各刺7~8 个小孔,每个针刺小孔滴加20 µL 孢子悬浮液覆盖,每个菌株处理2 枚叶片,以无菌水作为对照。接种后的叶片放置于铺有2层灭菌湿滤纸的塑料保鲜盒,于25 ℃光照/黑暗12 h交替的培养箱中培养并观察。待叶片发病后,从发病部位的病健交界处重新分离病原菌,与原接种菌株进行比较,若相同则符合柯赫氏法则。
1.2.3 病原菌鉴定 (1)形态学鉴定。将分离纯化的菌株接种至PDA 培养基,于25 ℃培养,分别在培养5 d 和12 d 时观察并记录菌落形态,在显微镜(型号:B203,重庆奥特光学仪器有限责任公司)下观察菌丝、分生孢子形态,并测量50 个分生孢子的大小。依据《真菌鉴定手册》[22]中的病原菌形态描述和Maharachchikumbura 等[23]提出的新分类描述对其进行形态学鉴定。
(2)多基因联合鉴定。采用CTAB 法提取22 个供试菌株的基因组DNA,以此为模板,使用表1引物分别对其rDNA-ITS、mtSSU、TUB 和TEF-1α 基因片段进行扩增。PCR 反应体系为25 µL:2× LA Premix Taq 12.5 µL,10 μmol·L-1的上下游引物各0.75 µL,DNA模板1.5 µL、灭菌超纯水(ddH2O)9.5 µL。反应程序:95 ℃预变性3 min;95 ℃变性30 s,适温退火45 s,72 ℃延伸90 s,35 个循环;72 ℃延伸10 min。以ddH2O 作为阴性对照。PCR 产物经1.0%琼脂糖凝胶电泳检测后,送至生工生物工程(上海)股份有限公司测序,将测序结果在NCBI(http://www.ncbi.nlm.nih.gov)上使用BLAST 进行序列比对,下载相似性高的序列及其模式菌株序列。使用MEGA7.0软件,将模式菌株及测序菌株序列按照最大似然法(ML)和neighbor-joining 法构建系统发育树,bootstrap设定为1000。
1.2.4 拮抗细菌与病菌的对峙培养 用直径5 mm打孔器在活化的病菌DT-5、MA-3、X-2菌落边缘打取菌丝块转接至另一个平板中央,在距平板中央20 mm处用接种环点接经LB 液体培养基活化的拮抗细菌菌株,以仅接种病菌处理作为对照。试验设置5 个拮抗细菌(NJ-1、NJ-4、S8、S1、T122F)和3个病菌,共计15 个处理,每处理3 次重复。28 ℃培养7 d 后,测量拮抗菌株与病菌之间的抑菌带宽度,根据抑菌带宽度评判其抑菌活性。
1.2.5 拮抗细菌对枇杷叶斑病的防治试验 将5 个拮抗细菌经LB 液体培养基活化培养后,按5%接种量转接至LB 液体培养基中,28 ℃、180 r·min-1振荡培养24 h,获得菌体浓度为106~107 CFU·mL-1发酵液备用。试验设置:5个拮抗细菌LB培养液20倍稀释液处理;450 g·L-1咪鲜胺水剂1000 倍液(商品推荐浓度)和10%苯醚甲环唑1000 倍液(商品推荐浓度)2 个药剂对照,以仅接种病菌作为阳性对照;以空白PDA 培养基作为阴性对照。每个处理2 枚叶片,在叶片主脉两侧各针刺4 个小孔,3 次重复。将各处理菌液和对照药液均匀喷洒在叶片上,以叶面刚好溢水为准。经4 h晾干后,采用叶片贴菌丝块接种法[24],即在培养12 d 的病菌DT-5 菌落平板边缘,用打孔器打取直径5 mm 菌饼,各针刺孔接种1个菌饼,菌丝面贴于叶片正面伤口处,接种后的叶片平放于铺有2 层灭菌湿滤纸的塑料保鲜盒。25 ℃光照/黑暗12 h交替培养15 d后,测量接种点病斑直径,计算病斑防治效果(公式1)。
1.2.6 拮抗细菌对枇杷果斑病的防治试验 在1.2.5 基础上,试验设置:5 个拮抗细菌LB 培养液20倍稀释液处理;450 g·L-1咪鲜胺水剂1000 倍液和1500 倍液(商品推荐浓度)2 个药剂对照,以仅喷施病菌作为阳性对照和仅喷施无菌水作为阴性对照。每个处理12 个果实,3 次重复。将果实浸泡于各处理菌液或药液30 s后取出,24 h晾干后,在果实表面均匀喷施浓度为1×105个·mL-1的病菌DT-5 孢子悬浮液,喷液量约为0.2 mL。经6 h晾干后,将各处理的果实平放于塑料保鲜盒。23~25 ℃室温下存放10 d后,调查果实发病情况。依据果实病斑面积进行分级,计算病情指数(公式2)和防治效果(公式3)。病情分级标准参考文献[25],并略加修改,0级:果实无病斑;1 级:病斑面积占果实面积的5%或以下;3 级:病斑面积占果实面积的>5%~10%;5级:病斑面积占果实面积>10%~30%;7 级:病斑面积占果实面积>30%~50%;9级:病斑面积占果实面积的50%以上。

1.3 数据统计与分析
使用Microsoft Excel 2007 和DPS V7.05 软件对试验数据进行统计分析,采用Duncan’s 新复极差法分析不同处理间的差异显著性。
2 结果与分析
2.1 枇杷叶斑病病害症状
田间病症观察发现,该病害初期在叶片上形成淡褐色小斑,后逐渐扩展为圆形或不规则形褐色斑,边缘呈淡棕色或暗褐色。病斑可从叶尖、叶缘扩展,后期病斑相连成大斑,中部灰白色,表面散生小黑点,为病原菌的分生孢子盘,病斑干燥易破裂(图1),严重时叶片畸形,呈大片焦枯状,叶片易脱落,影响树势和光合作用。

图1 枇杷叶斑病田间症状
Fig. 1 Symptoms of loquat leaf spot disease in the field
2.2 病原菌致病性测定
从不同种植区果园的发病植株叶片上共分离纯化出22 株病原菌,将其孢子悬浮液接种于健康叶片。试验表明接种12 d 后,接种菌株均表现出致病性,接种点出现圆形或不规则形近褐色病斑,发病症状与田间早期自然发病症状相似,以菌株DT-5接种10 d 后的发病症状为例(图2-A~B),而对照叶片未见任何症状(图2-C)。从回接的发病叶片病斑上可再次分离到接种病菌,表明分离的菌株均为枇杷叶斑病的致病菌。

图2 菌株DT-5 接种枇杷叶片10 d 后的症状
Fig. 2 Symptoms observed in the loquat leaves after inoculation with strain DT-5 for 10 days
2.3 病原菌菌落及分生孢子形态特征
菌株在PDA 平板上于25 ℃黑暗培养5 d,菌落形态近圆形,直径可达70 mm,正面为棉白色,气生菌丝发达,丛生呈絮状或绒毛状,菌丝表面层状起伏,边缘整齐,菌落背面为淡草黄色;培养12 d后,有的菌株表面出现黑色小粒点,即为分生孢子盘(图3-A~F)。菌丝无色、无隔,约2 μm 宽;分生孢子呈梭形、纺锤形,直或稍弯曲,大小为(17.36~29.76) μm ×(4.96~8.68)μm(n=50);有4 个分隔,隔膜处黑色素沉积明显,有5 个细胞,中间3 个细胞黄褐色或暗褐色,两端细胞(顶孢和尾孢)小,略呈三角形;顶孢透明,尾孢浅白色,孢子顶端着生附属丝2~3 根,丝状或渐细,弯曲,长14.88~37.20 μm,尾孢基部着生一根附属丝,管状,位于细胞中轴,长2.48~8.68 μm(图3-G~I)。根据菌落形态和分生孢子形态特征,初步将分离获得的菌株鉴定为新拟盘多毛孢属Neopestalotiopsis sp.。

图3 病原菌菌落和分生孢子形态特征
Fig. 3 Morphological characteristics of pathogenic fungus colonies and their conidia
2.4 病原菌多位点序列分析及其分子鉴定结果
对从枇杷叶斑病样本中分离的22 株菌株,分别对其rDNA-ITS、mtSSU、TUB 和TEF-1α 基因进行PCR 扩增、测序,获得长度分别为514、432、755 和570 bp 的目的基因序列,与GenBank 中相应基因序列(No.PQ345466、No.EU119118、No.OQ168328 和No.CP068086)的相似性分别为97.66%~100.00%、97.87% ~100.00% 、97.89% ~99.98% 和98.23% ~99.97%。以番茄早疫病菌Alternariasolani 作为外群,按照rDNA-ITS、TUB、mtSSU、TEF-1α 排序构建多基因系统发育树。结果表明,菌株Y4-4与参考菌株N. cubana的进化关系较近,聚为一个独立的进化支;P-2 与参考菌株N. formicarum、P-1 与N. eucalypticola、X-2 与N. clavispora 也分别聚为一个独立的进化支,各个种之间的区分度明显。此外,采用相同的方法分析其余18个菌株的鉴定结果(图4)。由此确定了西藏墨脱地区枇杷叶斑病病原为新拟盘多毛孢菌属中的4 个种,分别为N. clavispora(棒状新拟盘多毛孢)、N. eucalypticola、N. formicarum 和N. cubana(古巴新拟盘多毛孢),其出现频率分别为81.82%、4.55%、4.55%和9.10%。其中来自西让村(X-2、X-6、X-7)、德兴村(YL2-2、YL-4、Y1-1、Y4-2、Y7-1-2、YL3、DT-2、DT-4、DT-5)、地东村(D2-2)、玛迪村(MA-3、MA-6)、背崩村(B-4)、荷扎村(H5)和米日村(M1)共18 个菌株被鉴定为N. clavispora,为优势病原菌;来自墨脱村的菌株(P-1)被鉴定为N. eucalypticola,菌株(P-2)被鉴定为N. formicarum,德兴村的菌株(Y4-4)和西让村的菌株(X-5)被鉴定为N. cubana。

图4 基于rDNA-ITS、TUB、mtSSU 和TEF-1α 位点的新拟盘多毛孢系统发育树
Fig. 4 Phylogenetic tree of Neopestalotiopsis sp. based on rDNA-ITS, TUB, mtSSU and TEF-1α
2.5 拮抗细菌对病菌的抑制活性检测
通过平板对峙法检测发现,5 株供试拮抗细菌对病菌均具有较好的拮抗活性(表2,图5),对3株不同来源的棒状新拟盘多毛孢菌(DT-5、MA-3 和X-2)抑菌带宽度介于7.33~14.33 mm。在与各病菌对峙中,总体上拮抗细菌NJ-4 的抑菌活性最好,平均抑菌带宽度为13.22 mm;拮抗细菌S8 的抑菌效果较差,平均抑菌带宽度为8.11 mm。
图5 拮抗细菌对菌株DT-5 的对峙效果
Fig. 5 Antagonistic effect of antagonistic bacteria to strain DT-5
表2 拮抗细菌对新拟盘多毛孢菌的抑制效果
Table 2 Inhibitory effect of antagonistic bacteria against N. clavispora

注:同列数据后的不同小写字母表示在0.05 水平上差异显著。下同。
Note:Different small letters in the same column mean significant difference at 0.05 leve1. The same below.
菌株编号Strain number NJ-1 NJ-4 S8 S1 T122F抑菌带宽度 Inhibition width/mm DT-5 9.67±0.58 b 13.00±1.00 a 7.33±1.15 c 13.33±0.58 a 9.67±0.58 b MA-3 8.33±1.15 b 12.33±1.15 a 8.33±1.53 b 7.67±2.08 b 7.67±1.15 b X-2 7.33±2.08 b 14.33±0.58 a 8.67±2.31 b 10.00±1.00 b 7.33±1.15 b平均Average 8.44 13.22 8.11 10.33 8.22
2.6 拮抗细菌对枇杷叶斑病的防治效果
由表3 可知,接种处理15 d 后,接种病菌的阳性对照病斑直径达7.00 mm,而空白PDA 培养基处理的阴性对照未见发病。5种供试拮抗细菌20倍稀释发酵液处理的病斑平均直径介于1.31~3.63 mm,均显著低于阳性对照。S8、NJ-4、T122F和NJ-1处理对叶斑病的防治效果较好,防效分别为81.25%、69.64%、66.52%和63.84%,但明显低于450 g·L-1咪鲜胺水乳剂1000 倍液(94.64%)和10%苯醚甲环唑可湿性粉剂1000倍液(92.26%)处理的防效。
表3 拮抗细菌对枇杷叶斑病的防治效果
Table 3 Control effect of antagonistic bacteria against loquat leaf spot

处理Treatment S8 发酵液 S8 fermentation broth NJ-4发酵液 NJ-4 fermentation broth T122F发酵液 T122F fermentation broth NJ-1发酵液 NJ-1 fermentation broth S1发酵液 S1 fermentation broth 450 g·L-1咪鲜胺水乳剂 450 g·L-1 prochloraz EW 10%苯醚甲环唑可湿性粉剂 10% difenoconazole WP阴性对照Negative control阳性对照Positive control稀释倍数Dilute time 20 20 20 20 20 1000 1000防治效果Control effect/%81.25±21.65 ab 69.64±23.01 abc 66.52±11.61 abc 63.84±18.41 bc 48.21±9.78 c 94.64±9.28 a 92.26±13.40 a--病斑直径Spot diameter/mm 1.31±1.52 cde 2.13±1.61 bcd 2.34±0.81 bc 2.53±1.29 bc 3.63±0.68 b 0.38±0.65 de 0.54±0.94 de 0 e 7.00±1.04 a--
2.7 拮抗细菌对枇杷果斑病的防治效果
由表4可知,不同拮抗细菌处理对枇杷果斑病存在不同程度的抑制作用。接种处理10 d后,接种病菌的阳性对照病情指数为52.47,仅用无菌水处理的阴性对照病情指数为13.00(可能存在自然感染病菌的现象),5种供试拮抗细菌20倍稀释发酵液处理的病情指数介于26.60~40.88,均显著低于阳性对照。NJ-1和S8处理对枇杷果斑病防治效果较好,防效分别为49.31%和48.24%,但显著低于450 g·L-1咪鲜胺水乳剂1000 倍液(80.54%)和1500 倍液(76.64%)处理的防效。
表4 拮抗细菌对枇杷果斑病的防治效果
Table 4 Control effect of antagonistic bacteria against loquat fruit spot

处理Treatment S8 发酵液 S8 fermentation broth NJ-4发酵液 NJ-4 fermentation broth T122F发酵液 T122F fermentation broth NJ-1发酵液 NJ-1 fermentation broth S1发酵液 S1 fermentation broth 450 g·L-1咪鲜胺水乳剂450 g·L-1 prochloraz EW阴性对照Negative control阳性对照Positive control稀释倍数Dilute time 20 20 20 20 20 1000 1500防治效果Control effect/%48.24±9.72 b 22.09±6.04 c 39.68±6.76 b 49.31±1.11 b 28.45±5.90 c 80.54 ±4.73 a 76.64±3.56 a--病情指数Disease index 27.16±5.10 c 40.88±3.17 b 31.65±3.55 c 26.60±0.58 c 37.54±3.09 b 10.21±2.48 d 12.26±1.87 d 13.00±2.74 d 52.47±2.33 a--
3 讨 论
1988 年,陈国贵等[26]从国内枇杷传统产区浙江余杭、福建莆田、江苏昊县及安徽歙县等地的枇杷叶斑病病样中分离得到病原菌,经鉴定为拟盘多毛孢属真菌Pestalotia eriobotrifolia 和P. adusta 两个种。2014 年,姜琬等[27]对重庆及周边地区的叶斑病病原进行鉴定,鉴定致病菌为拟盘多毛孢属真菌Pestalotia spp.,基于rDNA-ITS、β-tubulin序列构建的系统发育树分析显示,该菌出现了2 个分枝。而Maharachchikumbura 等[23]根据形态及ITS、TUB 和TEF 基因相结合分析对黑盘孢科(Amphisphaeriaceae)拟盘多毛孢属真菌进行鉴定和种属地位划分,将拟盘多毛孢属(Pestalotiopsis)细分为3 个属:拟盘多毛孢属(Pestalotiopsis)、新拟盘多毛孢属(Neopestalotiopsis)和假拟盘多毛孢属(Pseudopestalotiopsis)。笔者从西藏墨脱地区的100 份枇杷叶斑病病样中分离获得22 株病原菌,经致病性测定、形态学特征观察及多位点序列分析共鉴定出4 个种,分别为新拟盘多毛孢菌属的N. clavispora、N. eucalypticola、N. formicarum 和N. cubana,由其引起的枇杷叶斑病在西藏地区为首次报道。其中,棒状新拟盘多毛孢菌N. clavispora是枇杷叶斑病的优势种,在该地区7 个枇杷种植区均有出现。新拟盘多毛孢属真菌在世界范围内广泛分布,在热带和亚热带生态系统中生物多样性尤其丰富,其宿主专一性不强,能够引起植物的多种病害,是重要的植物病原菌[28]。另据相关报道,棒状新拟盘多毛孢N. clavispora 还可引起香蕉叶斑病、苹果叶斑病、草莓枯萎病及黑老虎(五味子科的一种传统药用植物Kadsura coccinea)轮斑病[29-32]。因此,不仅要有效预防由新拟盘多毛孢菌引起的枇杷叶斑病,还应密切关注该类病菌在当地的发生动态及对其他作物的侵染致病情况。此外,在病样采集过程中还发现了一种胡麻叶斑病,该病害症状及孢子形态特殊,极易鉴别,由于仅在一个采样点出现,未对其进行具体描述和鉴定。
本研究供试的5 株拮抗细菌对棒状新拟盘多毛孢菌具有较好的拮抗作用,以拮抗细菌S8、NJ-4、T122F和NJ-1 20倍稀释发酵液处理对由该病菌菌丝侵染引起的枇杷叶斑病防效较好,其中又以S8、T122F 和NJ-1 处理对由该病菌孢子及其他病菌(存在自然感染)引起的枇杷果斑病防效较好,两种不同生境条件下防效不一致可能与拮抗细菌的作用对象不同或其定殖能力有关。经前期鉴定拮抗细菌S8和NJ-1为解淀粉芽孢杆菌,T122F为枯草芽孢杆菌,NJ-4 为贝莱斯芽孢杆菌,不同种类的生防菌对病菌的作用机制可能不一致。此外,枇杷营养丰富、含水量高,在采摘贮运过程中,一旦受到机械损伤,病原菌就很容易侵染伤口并大量繁殖,最终导致新鲜果品腐烂变质。蔡学清等[33]发现枯草芽孢杆菌BS-2、内生解淀粉芽孢杆菌TB2对荔枝采后病原菌具有较好的抑制作用,能够延长果实的储藏时间。棒状新拟盘多毛孢菌能引起枇杷采后果实病害的发生,加剧贮藏期果实腐烂,采用拮抗细菌S8、T122F和NJ-1的20倍稀释发酵液喷洒果实,能有效预防贮存期枇杷果实病害发生,也可用于枇杷果实保鲜处理,但菌剂的发酵条件优化及田间实际应用防治效果需进一步验证。2种供试药剂对棒状新拟盘多毛孢菌引起的枇杷病害均表现出较高的防效,表明病菌对药剂表现敏感,这可能与该地区枇杷生产上未使用药剂处理有关。
枇杷叶斑病一年四季均可发生,在温暖高湿条件下病害暴发性强,对枇杷产量造成严重影响,已成为危害枇杷安全生产的一类重要真菌性病害[34]。前期研究发现,在西藏墨脱地区的枇杷叶斑病病菌群体中出现了致病力和产孢能力强的菌株[35]。然而,当地枇杷种植者对该病害的严重性认识不足。随着枇杷种植年限的延长和种植规模的扩大,病原物得以长期积累,导致病害大范围发生。因此,在生产上应密切关注田间病害的发生动态,及时清理田间病叶,合理施肥以增强树势,必要时采用生防菌剂保护植株新梢,以降低叶斑病的发生率,减少果实携菌概率,对保护枇杷健果免受病菌侵染,延长果实保鲜期有着重要作用。
4 结 论
明确了西藏墨脱地区枇杷叶斑病的病原菌为新拟盘多毛孢菌N. clavispora、N. eucalypticola、N. formicarum 和N. cubana,其中N. clavispora 为优势病原菌。拮抗细菌S8、T122F 和NJ-1 对枇杷叶斑病表现出较好的生防潜力,病害防效分别为81.25%、66.52%和63.84%,并对贮存期枇杷果实具有一定的保鲜效果。研究结果可为当地枇杷新拟盘多毛孢叶斑病的绿色防控提供重要参考。
[1] 陈福如,陈元洪,翁启勇.枇杷病虫害诊治图谱[M]. 福州:福建科学技术出版社,2003.CHEN Furu,CHEN Yuanhong,WENG Qiyong. Graph of diagnosis of loquat pests and diseases[M]. Fuzhou:Fujian Science and Technology Press,2003.
[2] 张斌,耿坤,夏忠敏,邵昌余,吴琼,任轲亮. 贵阳地区枇杷常见病害调查初报[J]. 中国南方果树,2014,43(2):86-88.ZHANG Bin,GENG Kun,XIA Zhongmin,SHAO Changyu,WU Qiong,REN Keliang. Preliminary investigation of common diseases in Eriobotrya japonica and their damage degree in Guiyang region[J]. South China Fruits,2014,43(2):86-88.
[3] PERELLÓ A E,LARRAN S. First report of Pestalotiopsis guepini on loquat in Argentina[J]. Plant Disease,1999,83(7):695.
[4] CHEN Y,WANG W X,ZHANG A F,YANG X,XU Y L. First report of Pestalotiopsis theae on loquat (Eriobotrya japonica) in Anhui Province of China[J]. Plant Disease,2013,97(4):558.
[5] XIAO S,TANG Q,HUANG K H. First report of leaf blight of Eriobotrya japonica caused by Pestalotiopsis microspora in Anhui Province,China[J]. Plant Disease,2016,100(5):1014.
[6] 张丹华,张红楠,吴頔,梁国鲁. 重庆地区枇杷叶斑病病原初步鉴定及防治药剂室内筛选[J]. 中国南方果树,2017,46(4):102-106.ZHANG Danhua,ZHANG Hongnan,WU Di,LIANG Guolu.Preliminary identification of pathogen of loquat leaf spot disease in Chongqing area and screening of control agents[J]. South China Fruits,2017,46(4):102-106.
[7] 杨秀娟,陈福如,何玉仙. 枇杷拟盘多毛孢菌的生物学特性及杀菌剂的药效研究[J]. 福建农业学报,2003,18(2):89-92.YANG Xiujuan,CHEN Furu,HE Yuxian. Biological characteristics of Pestalotiopsis eriobotryfolia and control efficiencies of fungicides against the pathogen[J]. Fujian Journal of Agricultural Sciences,2003,18(2):89-92.
[8] 姜琬,徐波,胡军华,王莹,孙海艳,李晓林,汪卫星,郭启高,何桥,向素琼,梁国鲁. 枇杷拟盘多毛孢菌的室内及田间药剂筛选[J]. 中国南方果树,2014,43(1):49-51.JIANG Wan,XU Bo,HU Junhua,WANG Ying,SUN Haiyan,LI Xiaolin,WANG Weixing,GUO Qigao,HE Qiao,XIANG Suqiong,LIANG Guolu. Field and lab screening control of Pestalotiopsis eriobotryfolia[J]. South China Fruits,2014,43(1):49-51.
[9] 唐靖文,陈春旭,龙友华,王维东,夏忠敏,邵昌余. 6 种杀菌剂对枇杷灰斑病的室内毒力测定[J]. 中国园艺文摘,2016,32(4):51-53.TANG Jingwen,CHEN Chunxu,LONG Youhua,WANG Weidong,XIA Zhongmin,SHAO Changyu. Indoor toxicity determination of six fungicides on gray spot of loquat[J]. Chinese Horticulture Abstracts,2016,32(4):51-53.
[10] YANG M M,WEN S S,MAVRODI D V,MAVRODI O V,WETTSTEIN D V,THOMASHOW L S,GUO J H,WELLER D M. Biological control of wheat root diseases by the CLP-producing strain Pseudomonas fluorescens HC1-07[J]. Phytopathology,2014,104(3):248-256.
[11] GAO Z F,ZHANG B J,LIU H P,HAN J C,ZHANG Y J. Identification of endophytic Bacillus velezensis ZSY-1 strain and antifungal activity of its volatile compounds against Alternaria solani and Botrytis cinerea[J]. Biological Control,2017,105:27-39.
[12] AHMAD T,XING F G,NIE C R,CAO C Y,XIAO Y,YU X,MOOSA A,LIU Y. Biocontrol potential of lipopeptides produced by the novel Bacillus subtilis strain Y17B against postharvest Alternaria fruit rot of cherry[J]. Frontiers in Microbiology,2023,14:1150217.
[13] 叶晶晶,曹宁宁,吴建梅,胡祚忠,张剑飞. 生防芽孢杆菌的应用研究进展[J]. 西北农林科技大学学报(自然科学版),2014,42(8):185-190.YE Jingjing,CAO Ningning,WU Jianmei,HU Zuozhong,ZHANG Jianfei. Research progress on application of biocontrol Bacillus[J]. Journal of Northwest A & F University (Natural Science Edition),2014,42(8):185-190.
[14] 林胜红,潘晓梅,石晓玲,ALI I,刘震飞,于爽,张锦锋,牛振峰,田永强. 土壤霉菌菌丝球的筛选、鉴定及固定化菌丝球的应用[J]. 生物技术通报,2019,35(1):76-81.LIN Shenghong,PAN Xiaomei,SHI Xiaoling,ALI I,LIU Zhenfei,YU Shuang,ZHANG Jinfeng,NIU Zhenfeng,TIAN Yongqiang. Screening and identification of soil mycelial pellets and application of immobilized Mycelium[J]. Biotechnology Bulletin,2019,35(1):76-81.
[15] 张扬,郑建秋,谢丙炎,李健强,吴学宏,师迎春,马永军. 甘蓝枯萎病病原菌的鉴定[J]. 植物病理学报,2008,38(4):337-345.ZHANG Yang,ZHENG Jianqiu,XIE Bingyan,LI Jianqiang,WU Xuehong,SHI Yingchun,MA Yongjun. Identification on pathogen of cabbage wilt disease[J]. Acta Phytopathologica Sinica,2008,38(4):337-345.
[16] WHITE T J,BRUNS T D,LEE S B,TAYLOR J W,SNINSKY J,INNIS M A,GELFAND D H. Amplification and direct sequencing of fungal ribosomal RNA genes for phylogenetics[M]//INNIS M A,GELFAND D H,SNINSKY J J,WHITE T J. PCR Protocols:A guide to methods and applications. New York:Academic Press,1990:315-322.
[17] 郑荔,兰成忠,姚锦爱,阮宏椿,陈福如. 香蕉枯萎病菌线粒体小亚基(mtSSU)rDNA 的克隆及序列分析[J]. 福建农业学报,2012,27(8):826-830.ZHENG Li,LAN Chengzhong,YAO Jin’ai,RUAN Hongchun,CHEN Furu. Cloning and sequencing analysis of mitochondrial small subunit (mtSSU) rDNA sequence of Fusarium oxysporum f. sp. cubense[J]. Fujian Journal of Agricultural Sciences,2012,27(8):826-830.
[18] O’DONNELL K,CIGELNIK E. Two divergent intragenomic rDNA ITS2 types within a monophyletic lineage of the fungus Fusarium are nonorthologous[J]. Molecular Phylogenetics and Evolution,1997,7(1):103-116.
[19] RAHJOO V,ZAD J,JAVAN-NIKKHAH M,GOHARI A M,OKHOVVAT S M,BIHAMTA M R,RAZZAGHIAN J,KLEMSDAL S S. Morphological and molecular identification of Fusarium isolated from maize ears in Iran[J]. Journal of Plant Pathology,2008,90(3):463-468.
[20] O’DONNELL K,CIGELNIK E,NIRENBERG H I. Molecular systematics and phylogeography of the Gibberella fujikuroi species complex[J]. Mycologia,1998,90(3):465-493.
[21] 邱小燕,汤智鹏,张敏,荆海瑜. 一种适用于多数植物病原真菌的单孢分离方法[J]. 安徽农业科学,2011,39(9):5263-5264.QIU Xiaoyan,TANG Zhipeng,ZHANG Min,JIN Haiyu. Research on the isolation method of single spore of most plant pathogenic fungi[J]. Journal of Anhui Agricultural Sciences,2011,39(9):5263-5264.
[22] 魏景超. 真菌鉴定手册[M]. 上海:上海科学技术出版社,1979.WEI Jingchao. Fungal identification manual[M]. Shanghai:Shanghai Scientific & Technical Publishers,1979.
[23] MAHARACHCHIKUMBURA S S N,HYDE K D,GROENEWALD J Z,XU J,CROUS P W. Pestalotiopsis revisited[J].Studies in Mycology,2014,79(1):121-186.
[24] 谢晨昭,杨毅玲,李磊,李金云,王建辉,王慧敏. 拮抗放线菌B1 菌株鉴定及其防治番茄灰霉病的初步研究[J]. 植物保护学报,2008,35(4):300-306.XIE Chenzhao,YANG Yiling,LI Lei,LI Jinyun,WANG Jianhui,WANG Huimin. Taxonomy of antagonistic strain B1 and control effect of tomato gray mould[J]. Journal of Plant Protection,2008,35(4):300-306.
[25] QU H X,SUN G C,JIANG Y M,ZHU X R. Pathogenesis-related proteins in litchi after inoculation with Peronophythora lithii[J].Acta Horticulturae,2001(558):439-442.
[26] 陈国贵,曹若彬. 枇杷灰斑病病原菌的鉴定[J]. 植物病理学报,1988,18(4):208-212.CHEN Guogui,CAO Ruobin. Identification of pathogens of loquat leaf spot[J]. Acta Phytopathologica Sinica,1988,18(4):208-212.
[27] 姜琬,胡军华,向素琼,李晓林,孙海艳,郭启高,何桥,汪卫星,梁国鲁. 枇杷灰斑病菌鉴定与室内致病力评价体系建立[J].园艺学报,2014,41(增刊):2650.JIANG Wan,HU Junhua,XIANG Suqiong,LI Xiaolin,SUN Haiyan,GUO Qigao,HE Qiao,WANG Weixing,LIANG Guolu. Establishment of identification and pathogenicity evaluation system on loquat gray spot[J]. Acta Horticulturae Sinica,2014,41(Suppl.):2650.
[28] 宋玉. 拟盘多毛孢属(Pestalotiopsis)真菌系统学研究及条形码基因的评价[D]. 贵阳:贵州大学,2015.SONG Yu. Taxonomy of the genus Pestalotiopsis and evaluation of its DNA barcoding[D]. Guiyang:Guizhou University,2015.
[29] QI Y X,ZHANG H,PENG J,ZENG F Y,XIE Y X,YU Q F,ZHANG X. First report of Neopestalotiopsis clavispora causing leaf spot disease on banana (Musa acuminata) in China[J]. Plant Disease,2023,107(1):220.
[30] SHI J,LI B Y,WANG S L,ZHANG W,SHANG M Q,WANG Y Z,LIU B Y. Occurrence of Neopestalotiopsis clavispora causing apple leaf spot in China[J]. Agronomy,2024,14(8):1658.
[31] SHI J J,ZHANG X M,LIU Y,ZHANG Z H,WANG Z G,XUE C S,MA Y,WANG F. First report of Neopestalotiopsis clavispora causing calyx and receptacle blight on strawberry in China[J].Plant Disease,2022,106(4):1307.
[32] 谢津. 黑老虎轮斑病的病原鉴定和毒素成分分析及病害防治研究[D]. 南宁:广西大学,2020.XIE Jin. Pathogen identification,toxin analysis of the pathogen and control test of ring spot of Kadsura coccinea[D]. Nanning:Guangxi University,2020.
[33] 蔡学清,林娜,陈炜,胡方平. 荔枝霜疫霉的生防菌株与化学制剂的筛选[J]. 福建农林大学学报(自然科学版),2008,37(5):463-468.CAI Xueqing,LIN Na,CHEN Wei,HU Fangping. Selection of the biological agents and fungicides against Peronophthora litchii[J]. Journal of Fujian Agriculture and Forestry University(Natural Science Edition),2008,37(5):463-468.
[34] 陈依丽,陈雨琼,邓颖,李春雨,彭泽,杨向晖. 枇杷属植物叶片结构与叶斑病抗性的相关性研究[J]. 果树学报,2022,39(11):2133-2140.CHEN Yili,CHEN Yuqiong,DENG Ying,LI Chunyu,PENG Ze,YANG Xianghui. Analysis of correlation between leaf structure and resistance to leaf spot in Eriobotrya[J]. Journal of Fruit Science,2022,39(11):2133-2140.
[35] 甘林,姜帆,兰成忠,代玉立,何玉仙,杨秀娟. 西藏墨脱地区枇杷新拟盘多毛孢菌培养特征及致病力分析[J]. 东南园艺,2024,12(5):396-402.GAN Lin,JIANG Fan,LAN Chengzhong,DAI Yuli,HE Yuxian,YANG Xiujuan. Culture characteristics and pathogenicity of Neopestalotiopsis sp. to loquat in Medog areas of Tibet[J]. Southeast Horticulture,2024,12(5):396-402.